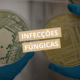

PAPILOSCOPIA FORENSE
A papiloscopia forense é uma das áreas mais consolidadas da perícia criminal, fundamentada no estudo dos desenhos papilares presentes nas extremidades dos dedos, palmas das mãos e plantas dos pés. Esses padrões permitem a identificação humana com elevado grau de confiabilidade, sendo utilizados tanto na investigação criminal quanto na identificação de pessoas.
No contexto da perícia criminal, a papiloscopia exerce papel central na vinculação de indivíduos a cenas de crime, objetos e vítimas, por meio da análise de impressões papilares encontradas como vestígios materiais.
Conceito e fundamentos da papiloscopia
A papiloscopia é a ciência que estuda os papilos, estruturas dérmicas responsáveis pela formação das cristas papilares. Esses desenhos se desenvolvem ainda no período embrionário e permanecem estáveis ao longo da vida, salvo em casos de destruição profunda do tecido cutâneo.
Três princípios científicos sustentam a identificação papiloscópica:
- Unicidade, pois cada padrão é exclusivo.
- Imutabilidade, já que não se altera com o tempo.
- Perpetuidade, uma vez que permanece desde a formação até após a morte.
Esses princípios conferem à papiloscopia elevado valor técnico e jurídico.
Papiloscopia na perícia criminal
Na perícia criminal, a papiloscopia é aplicada principalmente à análise de impressões latentes, que são marcas invisíveis deixadas por secreções naturais da pele quando ocorre contato com superfícies. Essas impressões podem ser reveladas por métodos físicos, químicos ou ópticos, de acordo com o tipo de superfície e as condições ambientais.
Após a revelação, as impressões são registradas e submetidas à comparação com padrões previamente existentes ou obtidos diretamente, por meio da análise morfológica de cristas, bifurcações, ilhas e terminações.
O resultado desse exame é formalizado em laudo papiloscópico, que pode estabelecer identidade, exclusão ou inconclusão, servindo como prova técnica no processo penal.
Metodologia de análise papiloscópica
O exame papiloscópico segue o protocolo internacionalmente aceito conhecido como ACE-V, composto por quatro etapas:
- Análise: da qualidade e quantidade de detalhes observáveis.
- Comparação: entre a impressão questionada e os padrões disponíveis.
- Avaliação: dos resultados obtidos.
- Verificação: por análise independente.
Esse método garante controle de erro, rastreabilidade e confiabilidade científica.
Importância na identificação humana
Além da vinculação de vestígios a indivíduos, a papiloscopia é amplamente empregada na identificação de cadáveres, pessoas desaparecidas e vítimas de eventos de grande impacto. Mesmo em situações de decomposição avançada, técnicas específicas permitem a recuperação das cristas papilares, possibilitando a obtenção de impressões válidas.
Papiloscopia, ciência e direito
A prova papiloscópica é classificada como prova técnica, produzida por especialista, e apresenta elevado valor probatório por se basear em critérios morfológicos objetivos e metodologia científica validada.
No processo penal, essa forma de identificação reduz a subjetividade e contribui para decisões fundamentadas em evidência material.
A papiloscopia forense representa a integração entre biologia, anatomia e metodologia científica aplicada à investigação criminal. Sua capacidade de individualizar pessoas a partir de vestígios mínimos mantém esse campo como um dos pilares da perícia criminal moderna, assegurando precisão, confiabilidade e relevância jurídica na produção da prova pericial.
Quer se especializar em Ciências Forenses e Perícia Criminal?
Aprofunde seus conhecimentos em técnicas periciais, análise de vestígios e investigação criminal com nossa Pós-graduação em Ciências Forenses e Perícia Criminal. Inscreva-se agora